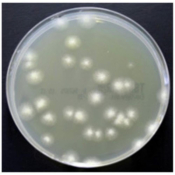

Microbiology Testing Identification
Accurate microbiological testing for sample identification.

Stock Code: 3064377
Manufacturer Part No: MB1588A
Manufacturer Part No: MB1588A
Stock Code: 3064382
Manufacturer Part No: R30950201
Manufacturer Part No: R30950201